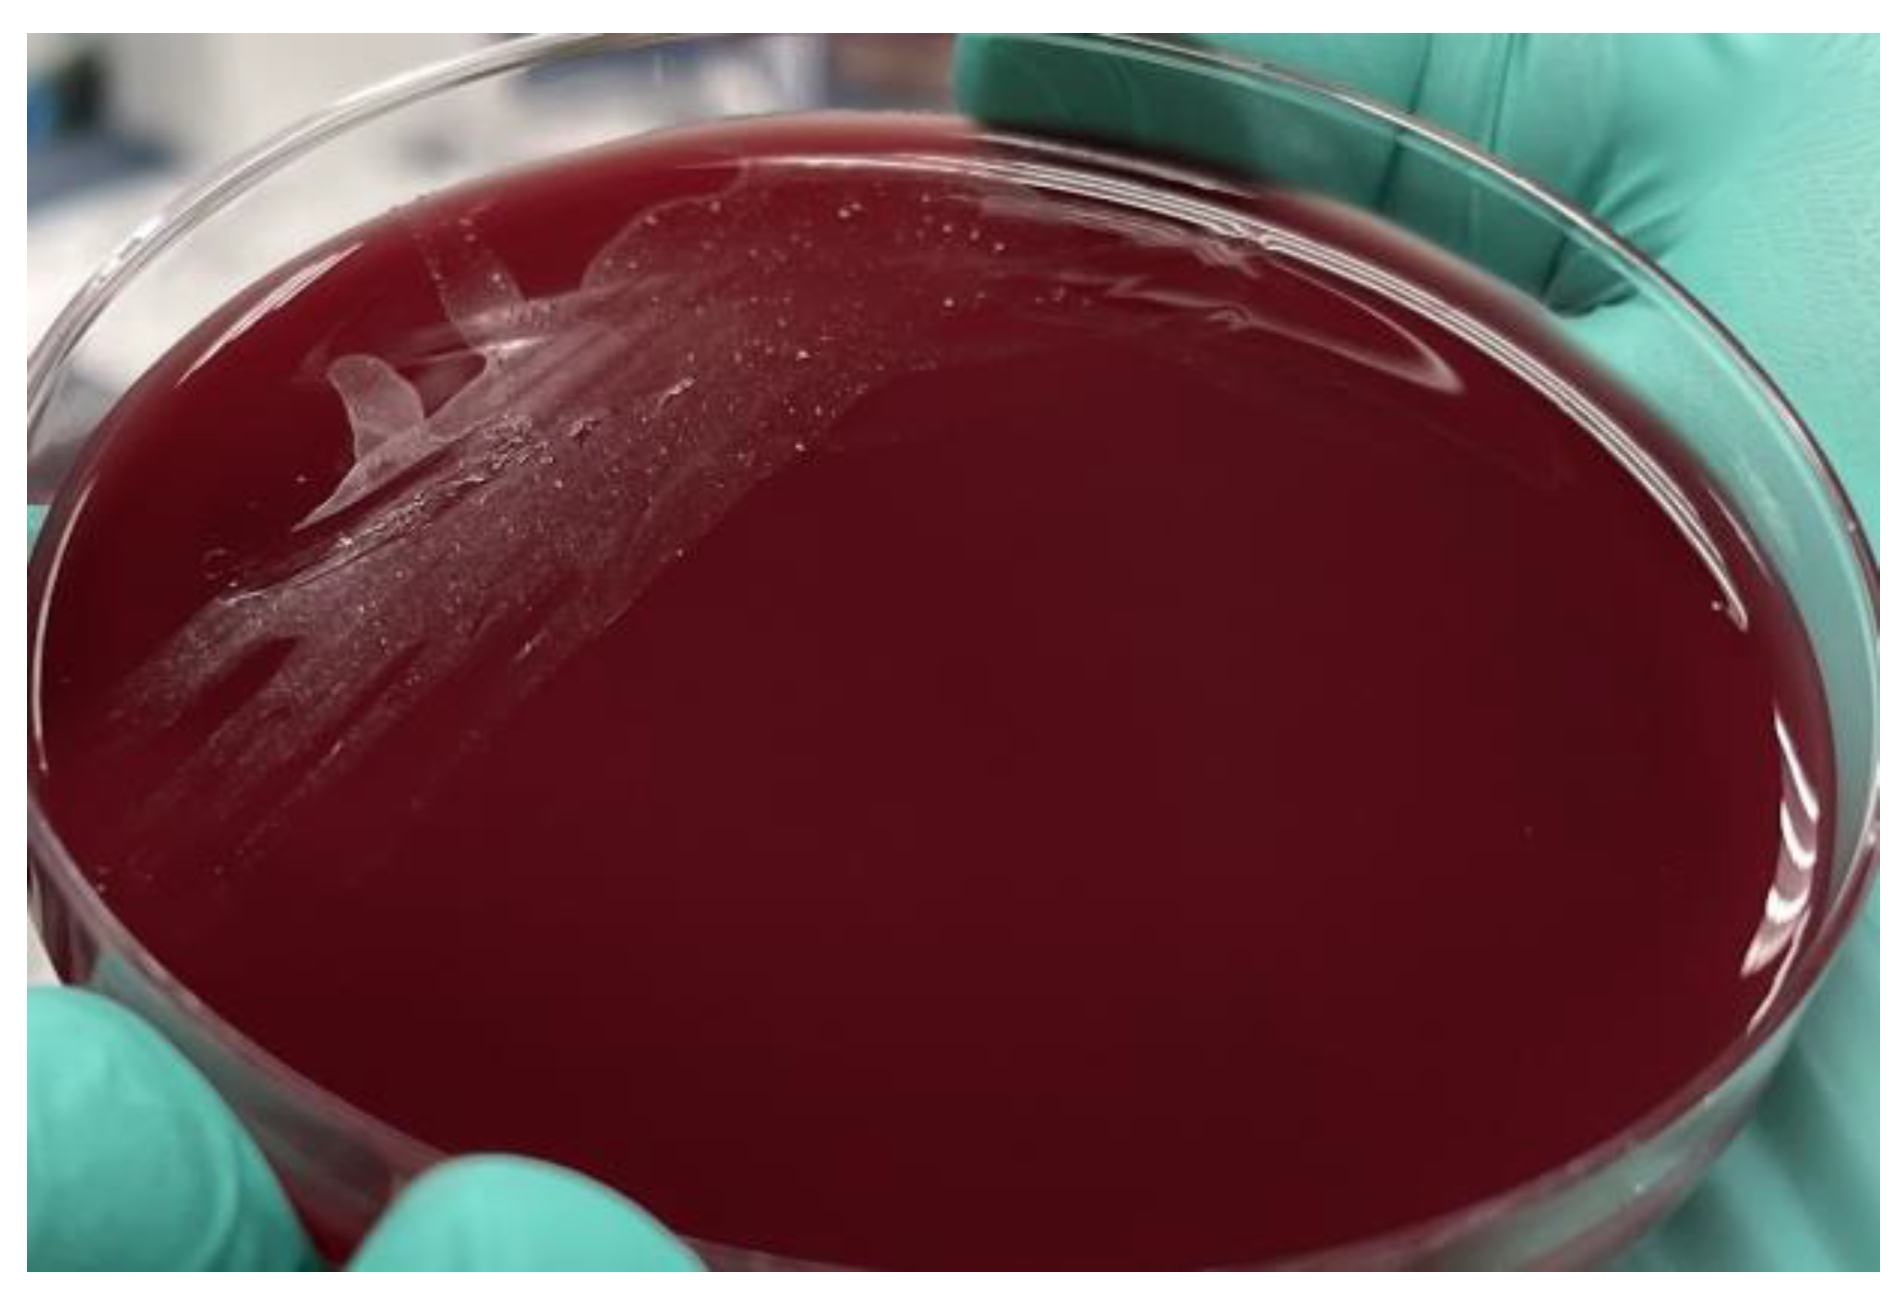

Capnocytophaga canimorsus Endocarditis Presenting with Leukocytoclastic Vasculitis and Glomerulonephritis
Abstract
1. Introduction
2. Case Presentation
3. Discussion
- (1)
- Microorganisms difficult to eradicate (e.g., persistent fungi);
- (2)
- Persistent bacteremia for >7 days despite adequate antimicrobial therapy;
- (3)
- Large, persistent TV vegetations (>20 mm);
- (4)
- Recurrent pulmonary emboli with or without concomitant right heart failure;
- (5)
- Right heart failure secondary to severe tricuspid regurgitation;
- (6)
- Cardiac abscess (more common in the setting of an infected prosthetic valve).
Supplementary Materials
Author Contributions
Funding
Data Availability Statement
Acknowledgments
Conflicts of Interest
References
- Lion, C.; Escande, F.; Burdin, J.C. Capnocytophaga canimorsus infections in human: Review of the literature and cases report. Eur. J. Epidemiol. 1996, 12, 521–533. [Google Scholar] [CrossRef] [PubMed]
- Hino, C.; Veltman, J. Capnocytophaga tricuspid valve endocarditis: A case report and literature review. Access Microbiol. 2022, 4, acmi000355. [Google Scholar] [CrossRef] [PubMed]
- Archer, S.L. Dysgonic fermenter 2 infection resulting in chronic glomerulonephritis. Can. Med. Assoc. J. 1985, 132, 657–660. [Google Scholar] [PubMed]
- Kannan, S.; Mattoo, T.K. Diffuse crescentic glomerulonephritis in bacterial endocarditis. Pediatr. Nephrol. 2001, 16, 423–428. [Google Scholar] [CrossRef] [PubMed]
- Li, M.; Kim, J.B.; Sastry, B.K.S.; Chen, M. Infective endocarditis. Lancet 2024, 404, 377–392. [Google Scholar] [CrossRef]
- Harrigan, A.; Murnaghan, K.; Robbins, M. Double valve infective endocarditis due to Capnocytophaga canimorsus. IDCases 2022, 27, e01448. [Google Scholar] [CrossRef]
- Hedman, E.; Fohlin, L.; Hellmark, B.; Aspevall, O.; Widerström, M. Five cases of C. canimorsus during a short period of time at Östersund Hospital, Sweden. Lakartidningen 2023, 120, 22150. [Google Scholar]
- Salazar Rodríguez, D.J.; Plata Ciézar, A.J.; Gaitán Román, D.; Urbano Carrillo, C.A. The dog, valves’ best friend: Infective endocarditis due to Capnocytophaga canimorsus-a case report. Eur. Heart J. Case Rep. 2023, 7, ytad228. [Google Scholar] [CrossRef]
- González Sans, D.; Carratalà Marín, P.; Guillen-Del-Castillo, A. Infective endocarditis due to Capnocytophaga canimorsus in an immunocompetent patient. Med. Clin. 2023, 160, 463–464. [Google Scholar] [CrossRef]
- O’Dwyer, M.; Houlihan, J.A.; O’Rourke, S.; Young, V.; O’Connell, B. An Infected Bicuspid Aortic Valve, an Anomalous Coronary Artery, and a Dog-Bitten Postman. J. Investig. Med. High Impact Case Rep. 2022, 10, 23247096221092283. [Google Scholar] [CrossRef]
- Janda, J.M.; Graves, M.H.; Lindquist, D.; Probert, W.S. Diagnosing Capnocytophaga canimorsus infections. Emerg. Infect. Dis. 2006, 12, 340–342. [Google Scholar] [CrossRef] [PubMed]
- Renzi, F.; Hess, E.; Dol, M.; Koudad, D.; Carlier, E.; Ohlén, M.; Moore, E.; Cornelis, G.R. Capsular serovars of virulent Capnocytophaga canimorsus are shared by the closely related species C. canis and C. cynodegmi. Emerg. Microbes Infect. 2018, 7, 124. [Google Scholar] [CrossRef] [PubMed]
- Suzuki, M.; Kimura, M.; Imaoka, K.; Yamada, A. Prevalence of Capnocytophaga canimorsus and Capnocytophaga cynodegmi in dogs and cats determined by using a newly established species-specific PCR. Vet. Microbiol. 2010, 144, 172–176. [Google Scholar] [CrossRef] [PubMed]
- Hess, E.; Renzi, F.; Karhunen, P.; Dol, M.; Lefèvre, A.; Antikainen, J.; Carlier, E.; Hästbacka, J.; Cornelis, G.R. Capnocytophaga canimorsus Capsular Serovar and Disease Severity, Helsinki Hospital District, Finland, 2000–2017. Emerg. Infect. Dis. 2018, 24, 2195–2201. [Google Scholar] [CrossRef]
- Umeda, K.; Hatakeyama, R.; Abe, T.; Takakura, K.; Wada, T.; Ogasawara, J.; Sanada, S.; Hase, A. Distribution of Capnocytophaga canimorsus in dogs and cats with genetic characterization of isolates. Vet. Microbiol. 2014, 171, 153–159. [Google Scholar] [CrossRef] [PubMed]
- Spentzouri, D.; Baliou, S.; Ioannou, P. Infective Endocarditis by Capnocytophaga Species—A Narrative Review. Medicina 2024, 60, 382. [Google Scholar] [CrossRef]
- Zajkowska, J.; Król, M.; Falkowski, D.; Syed, N.; Kamieńska, A. Capnocytophaga canimorsus—An underestimated danger after dog or cat bite—Review of literature. Przegl. Epidemiol. 2016, 70, 289–295. [Google Scholar]
- Davidson, D.M. Cardiovascular effects of alcohol. West. J. Med. 1989, 151, 430–439. [Google Scholar]
- Frontera, J.A.; Gradon, J.D. Right-side endocarditis in injection drug users: Review of proposed mechanisms of pathogenesis. Clin. Infect. Dis. 2000, 30, 374–379. [Google Scholar] [CrossRef]
- Sullam, P.M.; Drake, T.A.; Sande, M.A. Pathogenesis of endocarditis. Am. J. Med. 1985, 78, 110–115. [Google Scholar] [CrossRef]
- Pers, C.; Gahrn-Hansen, B.; Frederiksen, W. Capnocytophaga canimorsus septicemia in Denmark, 1982-1995: Review of 39 cases. Clin. Infect. Dis. 1996, 23, 71–75. [Google Scholar] [CrossRef] [PubMed]
- Kalb, R.; Kaplan, M.H.; Tenenbaum, M.J.; Joachim, G.R.; Samuels, S. Cutaneous infection at dog bite wounds associated with fulminant DF-2 septicemia. Am. J. Med. 1985, 78, 687–690. [Google Scholar] [CrossRef]
- Sandoe, J.A.T. Capnocytophaga canimorsus endocarditis. J. Med. Microbiol. 2004, 53, 245–248. [Google Scholar] [CrossRef] [PubMed]
- Butler, T.; Weaver, R.E.; Ramani, T.K.; Uyeda, C.T.; Bobo, R.A.; Ryu, J.S.; Kohler, R.B. Unidentified gram-negative rod infection. A new disease of man. Ann. Intern. Med. 1977, 86, 1–5. [Google Scholar] [CrossRef]
- Bhuiya, T.; Skavla, B.; Gandhi, H.; Makaryus, J.N.; Steinberg, B. A Diagnosis of Endocarditis in a Patient With Suspected Vasculitis. CASE 2023, 7, 346–348. [Google Scholar] [CrossRef] [PubMed]
- Loricera, J.; Blanco, R.; Hernández, J.L.; Calvo-Río, V.; Ortiz-Sanjuán, F.; Mata, C.; Rueda-Gotor, J.; Álvarez, L.; González-Vela, M.C.; González-López, M.A.; et al. Cutaneous vasculitis associated with severe bacterial infections. A study of 27 patients from a series of 766 cutaneous vasculitis. Clin. Exp. Rheumatol. 2015, 33, 36–43. [Google Scholar]
- Arlet, G.; Sanson-Le Pors, M.J.; Casin, I.M.; Ortenberg, M.; Perol, Y. In vitro susceptibility of 96 Capnocytophaga strains, including a beta-lactamase producer, to new beta-lactam antibiotics and six quinolones. Antimicrob. Agents Chemother. 1987, 31, 1283–1284. [Google Scholar] [CrossRef]
- Hayani, O.; Higginson, L.A.; Toye, B.; Burwash, I.G. Man’s best friend? Infective endocarditis due to Capnocytophaga canimorsus. Can. J. Cardiol. 2009, 25, e130–e132. [Google Scholar] [CrossRef]
- Chesdachai, S.; Tai, D.B.G.; Yetmar, Z.A.; Misra, A.; Ough, N.; Abu Saleh, O. The Characteristics of Capnocytophaga Infection: 10 Years of Experience. Open Forum Infect. Dis. 2021, 8, ofab175. [Google Scholar] [CrossRef]
- Peterson, C.J.; Abel, W.F.; Reddy, V.; Pfaff, K. Furry, Fomite, and Facultative Anaerobe: A Unique Case of Capnocytophaga canimorsus. Cureus 2023, 15, e47747. [Google Scholar] [CrossRef]
- Dayer, M.J.; Quintero-Martinez, J.A.; Thornhill, M.H.; Chambers, J.B.; Pettersson, G.B.; Baddour, L.M. Recent Insights Into Native Valve Infective Endocarditis: JACC Focus Seminar 4/4. J. Am. Coll. Cardiol. 2024, 83, 1431–1443. [Google Scholar] [CrossRef] [PubMed]
- Wang, A.; Fosbøl, E.L. Current recommendations and uncertainties for surgical treatment of infective endocarditis: A comparison of American and European cardiovascular guidelines. Eur. Heart J. 2022, 43, 1617–1625. [Google Scholar] [CrossRef] [PubMed]
- Shmueli, H.; Thomas, F.; Flint, N.; Setia, G.; Janjic, A.; Siegel, R.J. Right-Sided Infective Endocarditis 2020: Challenges and Updates in Diagnosis and Treatment. J. Am. Heart Assoc. 2020, 9, e017293. [Google Scholar] [CrossRef] [PubMed]
- Baddour, L.M.; Wilson, W.R.; Bayer, A.S.; Fowler, V.G., Jr.; Tleyjeh, I.M.; Rybak, M.J.; Barsic, B.; Lockhart, P.B.; Gewitz, M.H.; Levison, M.E.; et al. Infective Endocarditis in Adults: Diagnosis, Antimicrobial Therapy, and Management of Complications: A Scientific Statement for Healthcare Professionals From the American Heart Association. Circulation 2015, 132, 1435–1486. [Google Scholar] [CrossRef]
- Abrahamian, F.M.; Goldstein, E.J. Microbiology of animal bite wound infections. Clin. Microbiol. Rev. 2011, 24, 231–246. [Google Scholar] [CrossRef]

| Reference, Year | Age, Sex, Comorbidities | Source | Valve(s) Involved | Complications | Surgery | Antibiotics (Duration) | Outcome |
|---|---|---|---|---|---|---|---|
| Present case | 67 M, HTN, tobacco & alcohol use | Dog bite | TV | GN, anemia, PE, vegetation growth, MI, 3rd degree heart block | Yes | Cefepime (6 weeks) followed by pip-tazo | Recovered after surgery, died of unrelated cause |
| Harrigan [6], 2022 | 76 M, HTN, DM II, smoking, alcoholism | Dog bite | AV, MV | 3rd degree heart block; Atrial- ventricular fistula | Yes | Ceftriaxone (not specified) | Recovered |
| Hedman [7], 2023 | 80 F, healthy | Dog bite | AV | Septic shock, acute kidney injury, emboli to toes | No | Pip-tazo (7-days); ampicillin and ciprofloxacin (28 days) | Recovered; mild aortic regurg present 5 weeks after presentation |
| Salazar-Rodriguez [8], 2023 | 39 M, healthy | Dog bite | AV | Aortic root pseudoaneurysm; right atrium to left ventricle fistula | Yes | Pip-tazo (not specified); ceftriaxone (8 weeks), concurrent metronidazole (4 weeks) | Resolved |
| Gonzalez [9], 2023 | 80 F, HTN, aortic stenosis | Dog bite | AV, MV | T4-T9 epidural abscess; glenohumeral septic arthritis; 3rd degree heart block; aortic peri-annular abscess; stroke | No | Amoxicillin-clavulanate (not specified); ceftriaxone (not specified) | Died due to respiratory failure after stroke |
| O’Dwyer [10], 2022 | 33 M, bicuspid aortic valve, anomalous origin of RCA from LCA | Dog bite | AV | Aortic root abscess, aortic regurgitation, acute decompensated heart failure | Yes | Ceftriaxone (6 weeks), gentamicin and vancomycin (2 weeks) | Recovered |
| Characteristic | Result |
|---|---|
| % male (n = 29) | 69 |
| Age, yrs median (range) | 56 (24–80); Female 69 years (41–80); Male 51 years (24–76) |
| Comorbidities (n = 26) | Underlying cardiac diagnosis: 10 total; prosthetic valve (2); aortic stenosis (3); murmur (2); atrial myxoma (1); ICD (1); pacemaker (1); atrial fibrillation (1); bicuspid aortic valve (1); anomalous origin of RCA from LCA (1); rheumatic mitral valve disease (1) Hypertension (4); COPD (3); tobacco use (3); underlying cancer (3); type 2 diabetes (2); renal insufficiency (2); steroid use (1); dyslipidemia (1); nephrectomy (1); osteoarthritis (1) Alcohol abuse: 7 IV drug abuse: 1 None: 6 |
| Source (n= 28) | Dog bite: 12 (42.9%) Dog contact: 10 (35.7%) Dog scratch: 1 (7.4%) Dog feces: 1 (3.6%) Known dog exposure: 25/28 (89.3%) Unknown: 2 (7.1%) Lion bite: 1 (3.6%) |
| Valve(s) (n = 28 native valves) | AV only: 11/28 (39.3%) TV only: 8/28 (28.6%) MV only: 3/28 (10.7%) AV/TV: 3/28 (10.7%) AV/MV: 3/28 (10.7%) 2 prosthetic valves, 1 ICD |
| Complications | Cardiac: heart block (3); A-V fistula (2); valvular abscess (2); CHF (2); myocardial infarction; aortic root pseudoaneurysm; aortic regurgitation Embolic: pulmonary embolism (3); stroke; toe emboli Renal: glomerulonephritis (2); acute kidney injury (2) Other: anemia (4); septic shock; septic arthritis; epidural abscess |
| Surgery | 19/30 (63.3%) |
| Outcome, survival | 26/31 (83.9%) |
| Characteristic | Present Case | Archer, 1985 [3] | Kannan, 2001 [4] |
|---|---|---|---|
| Cr at presentation, mg/dL | 2.9 | 1.2 | 3.2 |
| Urine WBC/hpf | 396 | Not described | Not described |
| Urine RBC/hpf | 1450 | 60 | 20–40 |
| Proteinuria, g/24-h | 3.6 | 3.0 | 2+ proteinuria |
| Serum C3 level | Low | Low | Normal |
| Serum C4 level | Low | Normal | Normal |
| Cryoglobulins | Present; IgM monoclonal protein with kappa light chain specificity | Absent | Not described |
| ANA | Absent | Absent | Absent |
| Light microscopy | Glomeruli show endocapillary proliferation with abundant neutrophil infiltrate; reactive visceral and parietal epithelial cells are present forming minicrescents; Fibrin occ. associated w/the crescents; duplication of the glomerular basement membrane not identified; mild intimal thickening of arteries w/o vasculitis; moderate lymphoplasmacytic and neutrophil infiltrate of interstitium with occ. aggregates of eosinophils; neutrophil infiltrates of tubules w/occ. WBC casts. Rare necrotic tubules associated with WBC casts; moderate interstitial fibrosis |
Increased mesangium pushing into capillary loops. | Glomeruli show segmental necrosis and crescents of varying sizes. Heavy infiltrate of inflammatory cells seen in the interstitium. No vascular lesions seen. |
| Fluorescence microscopy |
Glomeruli are granularly stained: IgG 2-3+, IgA 1+, IgM 1+, C3 3+, C1q 1+, Fibrin Negative, Kappa 1+ and Lambda 1+ | Negative results for IgG and IgM and weakly positive results for complement. | 2+ granular IgM and C3 in a global mesangial and capillary wall distribution, and IgA, IgG, CIq, 1+ granular in a segmental mesangial distribution. |
| Electron microscopy | Ultrastructural study of parts of two glomeruli shows prominent endocapillary proliferation with numerous neutrophils in glomerular capillary lumen and mesangial matrix; poorly formed immune complex deposits primarily within the mesangial and paramesangial portions of glomeruli. Hump subepithelial deposits not identified; effacement of the overlying visceral epithelial foot processes associated w/ swelling of visceral epithelial cell cytoplasm and occ. poorly formed pseudovillous transformation. Vacuolar degeneration of the tubular epithelia. | Features consistent with type 1 membranoproliferative GN and not with type 2, or “dense deposit” disease | Glomeruli show cellular crescents, one associated w/ the rupture of the capillary wall. Finely granular and microfibrillary deposits seen in mesangium and paramesangium. Interstitium contained an inflammatory cell infiltrate. No vasculitis seen. |
| Overall impression | Resembles postinfectious GN | Type 1 membranoproliferative GN (decreased serum C3 level, increased mesangial tissue and capillary wall thickening; milder course than type 2); resembles postinfectious GN | Necrotizing and crescentic immune-complex glomerulonephritis. |
| Outcome | Required hemodialysis; no indication of improvement over 12 weeks at the time of death | Recovered | Recovered |
Disclaimer/Publisher’s Note: The statements, opinions and data contained in all publications are solely those of the individual author(s) and contributor(s) and not of MDPI and/or the editor(s). MDPI and/or the editor(s) disclaim responsibility for any injury to people or property resulting from any ideas, methods, instructions or products referred to in the content. |
© 2024 by the authors. Licensee MDPI, Basel, Switzerland. This article is an open access article distributed under the terms and conditions of the Creative Commons Attribution (CC BY) license (https://creativecommons.org/licenses/by/4.0/).
Share and Cite
Chandramohan, D.; Soni, N.J.; Awobajo-Otesanya, M.; Stilson, T.; Son, M.J.; Vinas, A.; Kanakia, R.; Soni, R.N.; Restrepo, M.I.; Anstead, G.M. Capnocytophaga canimorsus Endocarditis Presenting with Leukocytoclastic Vasculitis and Glomerulonephritis. Microorganisms 2024, 12, 2054. https://doi.org/10.3390/microorganisms12102054
Chandramohan D, Soni NJ, Awobajo-Otesanya M, Stilson T, Son MJ, Vinas A, Kanakia R, Soni RN, Restrepo MI, Anstead GM. Capnocytophaga canimorsus Endocarditis Presenting with Leukocytoclastic Vasculitis and Glomerulonephritis. Microorganisms. 2024; 12(10):2054. https://doi.org/10.3390/microorganisms12102054
Chicago/Turabian StyleChandramohan, Divya, Nilam J. Soni, Moyosore Awobajo-Otesanya, Terrence Stilson, Min Ji Son, Ariel Vinas, Rushit Kanakia, Riya N. Soni, Marcos I. Restrepo, and Gregory M. Anstead. 2024. "Capnocytophaga canimorsus Endocarditis Presenting with Leukocytoclastic Vasculitis and Glomerulonephritis" Microorganisms 12, no. 10: 2054. https://doi.org/10.3390/microorganisms12102054
APA StyleChandramohan, D., Soni, N. J., Awobajo-Otesanya, M., Stilson, T., Son, M. J., Vinas, A., Kanakia, R., Soni, R. N., Restrepo, M. I., & Anstead, G. M. (2024). Capnocytophaga canimorsus Endocarditis Presenting with Leukocytoclastic Vasculitis and Glomerulonephritis. Microorganisms, 12(10), 2054. https://doi.org/10.3390/microorganisms12102054

